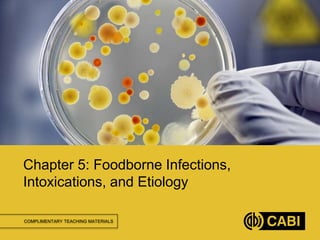
COMPLIMENTARY TEACHING MATERIALS
Chapter 5: Foodborne Infections,
Intoxications, and Etiology
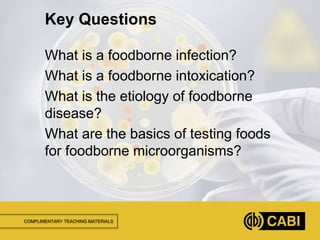
COMPLIMENTARY TEACHING MATERIALS
What is a foodborne infection?
What is a foodborne intoxication?
What is the etiology of foodborne
disease?
What are the basics of testing foods
for foodborne microorganisms?
Key Questions
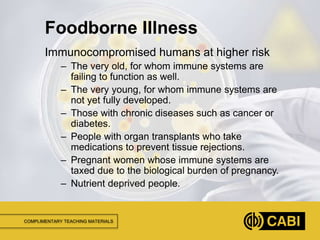
COMPLIMENTARY TEACHING MATERIALS
Immunocompromised humans at higher risk
– The very old, for whom immune systems are
failing to function as well.
– The very young, for whom immune systems are
not yet fully developed.
– Those with chronic diseases such as cancer or
diabetes.
– People with organ transplants who take
medications to prevent tissue rejections.
– Pregnant women whose immune systems are
taxed due to the biological burden of pregnancy.
– Nutrient deprived people.
Foodborne Illness
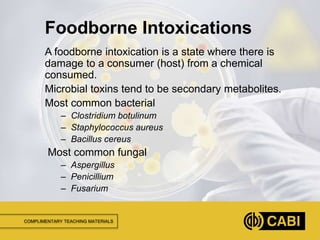
COMPLIMENTARY TEACHING MATERIALS
A foodborne intoxication is a state where there is
damage to a consumer (host) from a chemical
consumed.
Microbial toxins tend to be secondary metabolites.
Most common bacterial
– Clostridium botulinum
– Staphylococcus aureus
– Bacillus cereus
Most common fungal
– Aspergillus
– Penicillium
– Fusarium
Foodborne Intoxications
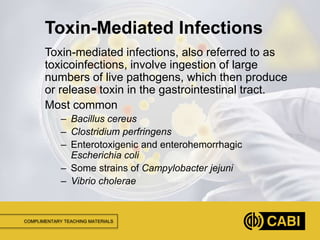
COMPLIMENTARY TEACHING MATERIALS
Toxin-mediated infections, also referred to as
toxicoinfections, involve ingestion of large
numbers of live pathogens, which then produce
or release toxin in the gastrointestinal tract.
Most common
– Bacillus cereus
– Clostridium perfringens
– Enterotoxigenic and enterohemorrhagic
Escherichia coli
– Some strains of Campylobacter jejuni
– Vibrio cholerae
Toxin-Mediated Infections
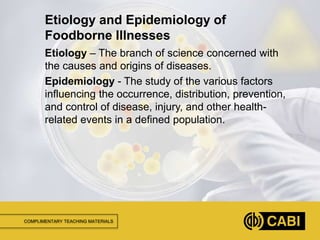
COMPLIMENTARY TEACHING MATERIALS
Etiology – The branch of science concerned with
the causes and origins of diseases.
Epidemiology - The study of the various factors
influencing the occurrence, distribution, prevention,
and control of disease, injury, and other health-
related events in a defined population.
Etiology and Epidemiology of
Foodborne Illnesses
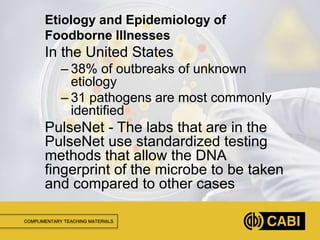
COMPLIMENTARY TEACHING MATERIALS
In the United States
– 38% of outbreaks of unknown
etiology
– 31 pathogens are most commonly
identified
PulseNet - The labs that are in the
PulseNet use standardized testing
methods that allow the DNA
fingerprint of the microbe to be taken
and compared to other cases
Etiology and Epidemiology of
Foodborne Illnesses
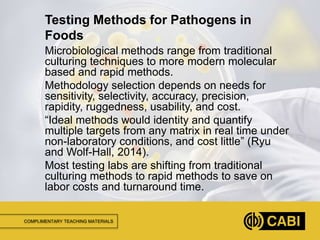
COMPLIMENTARY TEACHING MATERIALS
Microbiological methods range from traditional
culturing techniques to more modern molecular
based and rapid methods.
Methodology selection depends on needs for
sensitivity, selectivity, accuracy, precision,
rapidity, ruggedness, usability, and cost.
“Ideal methods would identity and quantify
multiple targets from any matrix in real time under
non-laboratory conditions, and cost little” (Ryu
and Wolf-Hall, 2014).
Most testing labs are shifting from traditional
culturing methods to rapid methods to save on
labor costs and turnaround time.
Testing Methods for Pathogens in
Foods
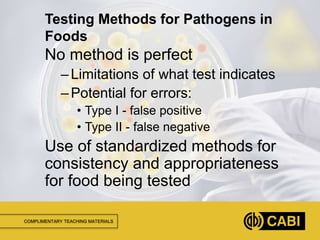
COMPLIMENTARY TEACHING MATERIALS
No method is perfect
–Limitations of what test indicates
–Potential for errors:
• Type I - false positive
• Type II - false negative
Use of standardized methods for
consistency and appropriateness
for food being tested
Testing Methods for Pathogens in
Foods
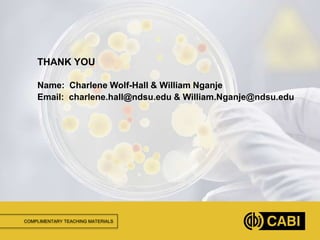
COMPLIMENTARY TEACHING MATERIALS
THANK YOU
Name: Charlene Wolf-Hall & William Nganje
Email: charlene.hall@ndsu.edu & William.Nganje@ndsu.edu

This document provides an overview of microbial food safety and foodborne illnesses. It defines foodborne infections as diseases resulting from eating food containing living pathogens, and foodborne intoxications as damage from toxins produced by microbes in food. The etiology of foodborne illness is discussed, along with those most at risk. Testing methods for foodborne pathogens are also summarized, including traditional culturing and newer molecular techniques. Limitations and the need for standardized testing methods are also addressed.